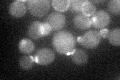
YBR200W
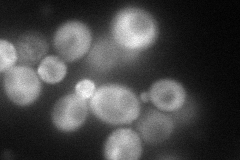
YBR200W
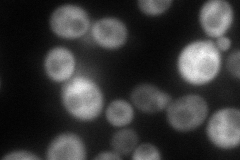
YBR200W
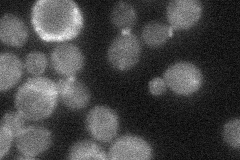
YBR200W
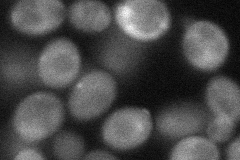
YBR200W
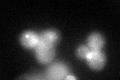
YBR200W
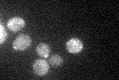
YBR200W

View description
Protein containing SH3-domains, involved in establishing cell polarity and morphogenesis; functions as a scaffold protein for complexes that include Cdc24p, Ste5p, Ste20p, and Rsr1p
Localization:
Intensity:
Fold change:
Significance:
-
C’ GFP library in SD
bud neckN/A -
N' NOP1pr-GFP in SD
cytosol,bud98.4401 -
N' TEF2pr-mCherry in SD
bud120.378 -
N' NATIVEpr-GFP in SD
bud neck28.6204 -
N' TEF2pr-VC and Cyto-VN in SD
cytosol,bud49.3763 -
C’ GFP library in SD+DTT
bud neck35.971.1No -
C’ GFP library in SD+H2O2

bud neck34.911.07No -
C’ GFP library in Starvation Media
cytosol31.840.97No -
C’ GFP library on the background of Pup2-DaMP

bud neck -
C’ GFP library on the background of CCT mutant

bud neck36.13761.10919No
